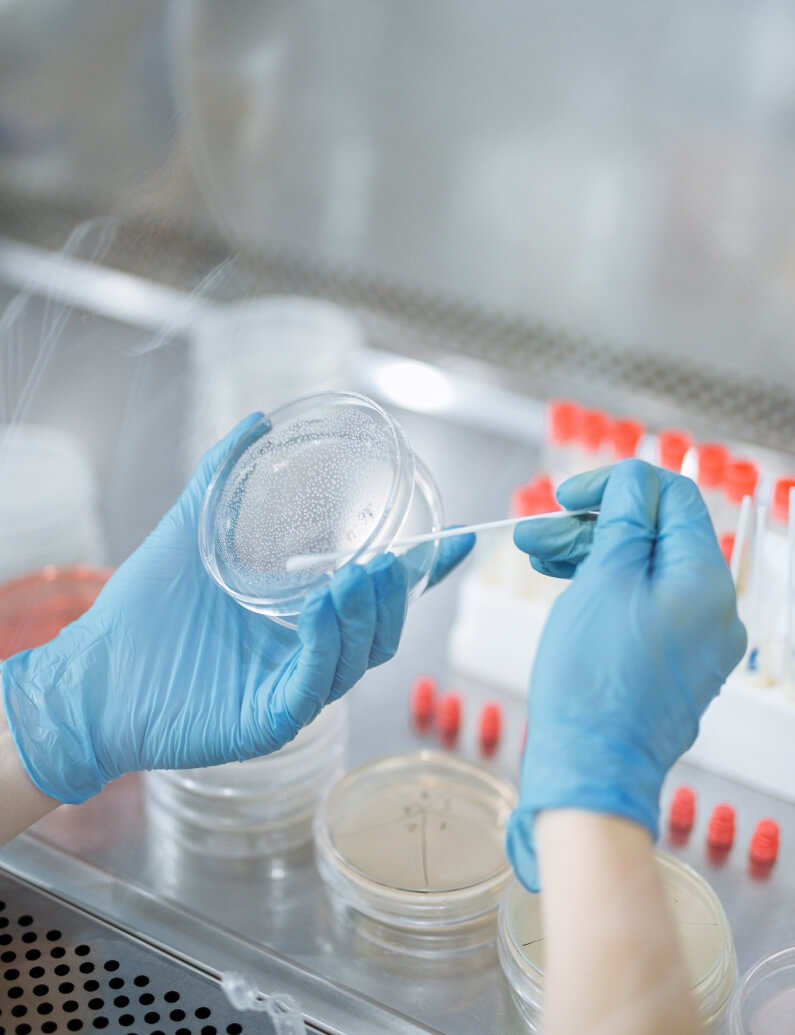

About PCR
Modern molecular diagnostics method
State-of-the-art polymerase chain reaction method has proven effective for a wide range of clinical studies.

PCR uses in clinical practice
PCR assays have become firmly established in daily routine of research and clinical laboratories around the globe. Range of tasks solved by real-time PCR is constantly widening.

-
Diagnostics of infectious diseases
-
Detection of genetic disorders
-
Qualitative and quantitative analysis of microbiota composition
-
Viral load testing
-
Assessment of hereditary predisposition to various diseases
-
Prenatal and neonatal screening
-
Analysis of gene expression levels in scientific research
-
Scientific and clinical research
Difference from other methods
- PCR not only detects an infectious agent but also allows for its quantitative assessment.
- It requires only a minimal amount of biological material for analysis.
- It accurately identifies microorganisms with different cultivation properties, including non-cultivable ones.
- PCR is a direct method: it detects the infectious agent itself, rather than assessing the body's immune response.
- Simpler transportation and storage of samples – there is no need to maintain microorganism viability.
- Objective interpretation of test results.
- Significantly cheaper and faster compared to NGS.
PCR: Workflow
What are we studying?
Depending on the task, any biomaterial can be used for PCR assay: blood, epithelial cell scrapes, urine, feces, etc. Biomaterial collection is normally performed by medical staff, however, in some cases, it can be self-collected and submitted to the laboratory.
-
Sample preparation
Nucleic acid extraction from biomaterial.
-
Amplification
Copying specific nucleic acid fragments. The cycle is repeated from 20 to 50 times. The number of DNA copies increases by tens of thousands of times, which allows for precise diagnostics.
-
Results
After the assay, the data is automatically processed and uploaded to LIS, which allows to access the results of any patients at any time and group them, if necessary.

Ask questions
Please note that the specialists of the DNA Technology company provide consultations exclusively to medical specialists on the application and research features. Requests related to the appointment, delivery, or interpretation of tests are not considered. For relevant information, we recommend contacting the laboratory directly.








